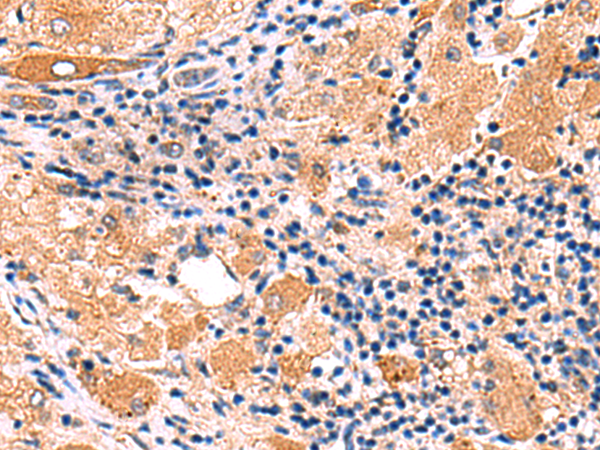

克隆類型: rabbit polyclonal
技術規(guī)格
|
Background: |
Produced by macrophages, IFN-alpha have antiviral activities. Interferon stimulates the production of two enzymes: a protein kinase and an oligoadenylate synthetase. |
|
Applications: |
ELISA, WB, IHC |
|
Name of antibody: |
IFNA1/IFNA13 |
|
Immunogen: |
Synthetic peptide of human IFNA1/IFNA13 |
|
Full name: |
interferon alpha 1/13 |
|
SwissProt: |
P01562 |
|
ELISA Recommended dilution: |
5000-10000 |
|
IHC positive control: |
Human tonsil and Human liver cancer |
|
IHC Recommend dilution: |
30-150 |
|
WB Predicted band size: |
22 kDa |
|
WB Positive control: |
Mouse liver tissue lysate |
|
WB Recommended dilution: |
200-1000 |

購物車
幫助
021-54845833/15800441009
